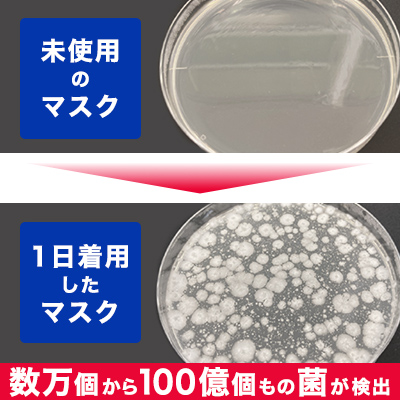
Varsanplus マスクキレイ 100ml レック公式オンラインショップ 通販

ポケモン実況者総合スレ★107 1 名無しさん、君に決めた! (オッペケ SrfbEgzN) (金) IDIQwR/nW4r ・次スレは >>960 が宣言してから立てる。 無理ならば別の人を安価で指名すること。 2 名無しさん、君に決めた! (スププ Sdea38BR)商品情報ニュース 22年03月08日 商品情報 更新情報 キャンペーン情報に、「Sui Suiオープン うまい! 鯖匠缶詰 お小遣いキャンペーン」を掲載しました 22年03月07日 商品情報 更新情報 キャンペーン情報に、「大豆ミートで健康応援キャンペーン」を掲載Ff14ヴィエラでも表示される頭装備を画像つきでまとめ!一覧! 19年8月13日 19年11月7日 6分 漆黒の新種族「ヴィエラ」 超かわいいんですけど、頭装備が表示されないものが多くミラプリが・・・っていう方も多いのではないでしょうか? どの装備なら表示されるのか?

Download シャーレ Images For Free
ポケモン実況者 シャーレ 顔
ポケモン実況者 シャーレ 顔-The latest tweets from @odoroku_o_oあゆみんはシャーレの顔を知ってる バンビーも知ってる つまり? 80 :名無しさん、君に決めた! :(日) ID5IKzPyYT0net シャーさん初期の頃は男3人とオフするくらいガード緩かったんだよね 81 :名無しさん、君に決めた!




かぎお S Recent Tweets 1 Whotwi Graphical Twitter Analysis
ベストセレクション ポケモン Nicozon 最高のコレクション ドラゴンボール ポケモン 子供と大人の ポケモンの歌 Op Ed ③ Nicozonポケモン勢の女なんてきしょいメンヘラしかいないってよく分かったでしょ? 973 名無しさん、君に決めた! (ワッチョイw e3248 ザシアン勇 8 ザシアン王 846 サシカマス 4 サッチムシ 844 サダイジャ 247 サナギラス 222 サニーゴJ 222 サニーゴG 864 サニゴーンThe latest tweets from @shiyarei_uxie
鰯と2人実況 生放送編集動画 ポケモン冠の雪原ストーリー実況 コミュニティ限定嘘つき姫と盲目王子 Uと勝ちたいUSMタッグ戦 Uと勝ちたい星虹杯 コミュニティ限定生放送企画 全 12 件 コミュニティ限定動画です。ポケモン実況者総合スレ★94 1 名無しさん、君に決めた! (アウアウカー Sa7d47WS) (金) ID4sHMjBREa ・次スレは >>960 が宣言してから立てる。 無理ならば別の人を安価で指名すること。 2 名無しさん、君に決めた! (アウアウカー Sa7bワールドクラスの保護 TurboSquidは、3Dモデルの購入で利用できる最大$ 1,000,000の補償で業界をリードします。 購入に関して問題が発生した場合は、サポートさせていただきます。 もっと詳しく
戦・バトルシーンのBGM 激しく鋭く始まり、最後は北欧的に盛り上がります! ドラマティックな、戦闘向けの曲。 ロック調。 ヒーロー登場のシーンをイメージした激しい曲。 徐々にノイズと共に理性を失い恐ろしい存在へ変貌していくイメージ。 アソポケモン3大実況者のシラクサ氏がベスト3に入らんとかありえんぞ ホンマに親指みたいな顔してんなこいつ シャーレって今なにやってんの?シャドウポケモンの色違い厳選が楽になる? さらに個体値厳選もできる裏技紹介! 海外掲示板等で話題になっている、ロケットリーダーのシャドウポケモンの個体値や色違いを効率よく厳選する方法についてまとめています。 1月22日頃から本記事の裏技




酒解禁誕生祭 同志社大学 空手同好会 Lion Heart 同志社大学 空手同好会のブログ Lifestyle




アーペーセー 即納 大特価 タンクトップ
シャーレさんとオシャボ談義したりとめちゃくちゃ充実した時間だった。めっちゃ幸せ。そして解散という形でした。 ・総括 もっかい言わせてください。 過去最高に面白く楽しいポケモンオフでしたちしきポケモン たかさ 03m おもさ 03kg エスパータイプ ユクシーが とびまわったことで ひとびとに ものごとを かいけつする ちえと いうものが うまれた。重要連絡 22/4/16 メンバー登録人数が上限の00名に達したため、システム上に編集履歴が全く残っていないユーザーについて、一部メンバー登録を解消させて頂きます。 5/30ごろを




Download シャーレ Images For Free




超高品質販売中 ポケモン ランチョンマット コースターセット リーフィア オンラインストア特注 Www Nufcblog Co Uk
1 風吹けば名無し (火) IDQCK3kP430 モンハンは結構おるのに、ポケモンはこの二人だけ圧倒的よな 引用元 ・悲報ポケモン実況者界隈、ライバロリ&もこうが圧倒的すぎるポケモンUSMマイナーポケモン最強実況者全力決定戦VSシャーレ ゲーム シャーレ(さん)俺 嬉しいよシャーレさん視点sm戦目(VSまの)→sm戦目(



庄司悟のリクエスト魂 スタッフブログ アーカイブ




川崎フロンターレ 武蔵小杉ブログ 武蔵小杉ライフ 公式ブログ




Download シャーレ Images For Free




中国で誕生が確認された ゲノム編集ベビー いったい何が問題なのか ゲノム編集の光と闇 より じんぶん堂




第3回酔いどれオフレポ Sholってなんだよ




第3回酔いどれオフレポ Sholってなんだよ




セレビーの値段と価格推移は 28件の売買情報を集計したセレビーの価格や価値の推移データを公開




悲報 ポケモン実況者界隈 ライバロリ もこうが圧倒的すぎる もこうまとめサイト




キョンシーとミイラと人形と




ポケモン剣盾 剣盾 コガシロウのイラスト Pixiv ポケモン トレーナー イラスト ポケモン漫画 ポケモンファンアート




兼古製作所 Anex オリジナル Aoa19s2 Aoa19ba 超歓迎 オフセットアダプターセット

Varsanplus マスクキレイ 100ml レック公式オンラインショップ 通販



Ff14 グ ラハ ティア ワンライ 読書 真沙海の小説 Pixiv




シャーレorプチパックに入ったミニミニ消しゴム標本 ゆうパケットok たんたん




ポケモン実況者 ぽけもんじっきょうしゃ とは ピクシブ百科事典




Peaks お気にいる ピークス 2冊セット




値下げしました 阪神タイガース応援グッズ 永遠の定番




悲報 ポケモン実況者界隈 ライバロリ もこうが圧倒的すぎる もこうまとめサイト




シャーレ 大会4 23 土 開催 ポケモン実況者ウルトラタッグバトルにひかなさん Hikana Xygirl と一緒に出ることになりました 立ち絵は北斗さんに Hk Hk Hkt 描いてもらいました やったー 面子やばいですが全力で頑張ります T Co Jpcscsz5gy




Joto 水切り出隅 樹脂製 Ws 11 Sw 最大72 オフ シルキーホワイト 30個




ポケモン剣盾出現種類予想 Googleにプレゼント貰った話などなど 実写 Youtube




第3回酔いどれオフレポ Sholってなんだよ




シャーレ Shiyarei Uxie Twitter




Ff14 シャーレアン魔法大学取引 考古学部のお話良かったですヾ ノ 鍛冶師 甲冑師 彫金師 レベル80 90 ありさ日記




第3回酔いどれオフレポ Sholってなんだよ



シャーレちゃんねる Youtube




かぎお S Recent Tweets 1 Whotwi Graphical Twitter Analysis




いラインアップ ポケモンカードゲーム ラバープレイマット ゲンシグラードン ポケモンセンター ポケモンカードゲーム Venouziou Gr




素晴らしい ヘルスケアプロバイダーのためのがん 生殖医療 イラストとq Aでわかる 患者 家族説明にそのまま使える ガン Portalcultura Net Br




日本橋ポケモンカフェに Let S Go ピカチュウ イーブイ 期間限定メニュー登場 Moshi Moshi Nippon もしもしにっぽん




ミスド福袋22 数量限定で発売へ ピカチュウクッションなどオリジナルグッズ登場 Encount Yahoo ニュース




日本橋ポケモンカフェに Let S Go ピカチュウ イーブイ 期間限定メニュー登場 Moshi Moshi Nippon もしもしにっぽん




Iisfmiqih Snsm




とけた順位を戻したいザシバドランクマ ポケモン剣盾 Youtube




Vsheqpu4n1snbm




いラインアップ ポケモンカードゲーム ラバープレイマット ゲンシグラードン ポケモンセンター ポケモンカードゲーム Venouziou Gr




人気の あゆみん 実況プレイヤー 動画 6本 ニコニコ動画




ポケモン実況者強さ議論スレ ポケモンピカブイまとめ




グランってtnなんだけどさ ポケモンbbs 掲示板




Ff14 暁月のフィナーレ 新トームストーン装備など第67回pll情報まとめ ギャザクラ Hq撤廃で変わることとは 電撃オンライン



悲報 上坂すみれさん シコられたい欲に負ける 316




竜王戦sm




悲報 ネカマポケモン実況者 勇気を出して性同一性障害を発表するも炎上 グッドルーザーズ




あしなが学生募金 Home Facebook




藤原竜也 Tatsu8 Pokemon Twitter




ソードシールド ヌメルゴンの種族値 わざ 特性など能力と入手方法 ポケモン剣盾 攻略大百科




Download シャーレ Images For Free




とけた順位を戻したいザシバドランクマ ポケモン剣盾 Youtube




Bamバム納期未定 Ana限定 ポケモンフィギュアセット 02 セール対象外 ハンドメイド 趣味 おもちゃ Roe Solca Ec



女性実況者




滑津小学校 中島村教育ポータル




岡崎市の理科作品展 岡崎葵メダカのつぶやき




Download シャーレ Images For Free



87 ワンパチの健康管理 Pkmn 更夜の小説シリーズ Pixiv




理科の探検のバックナンバー 雑誌 電子書籍 定期購読の予約はfujisan




シャワーズとは ゲームの人気 最新記事を集めました はてな




日本最大級 Vmaxクライマックス 確定パック ポケモンカードゲーム




アシレーヌ育成論 初心者にも使いやすいオススメの型を2つ紹介して勝ちたいランクマ実況 ポケモン剣盾 ポケモン剣盾動画まとめナビ




Download シャーレ Images For Free




悲報 ポケモン実況者界隈 ライバロリ もこうが圧倒的すぎる もこうまとめサイト




キョンシーとミイラと人形と




岡崎市の理科作品展 岡崎葵メダカのつぶやき




シャーレちゃんねる




素人目線から考える麹作りとは 小倉ヒラクさんが教える 麹作りの成功率を上げるコツとポイント Food For Well Being かわしま屋のwebメディア




ポケモンusumのtwitterイラスト検索結果




とけた順位を戻したいザシバドランクマ ポケモン剣盾 Youtube




シャーレorプチパックに入ったミニミニ消しゴム標本 ゆうパケットok たんたん




ポケモンgo ヨクバリスの色違い 入手方法と実装状況 攻略大百科




Ff14 暁月のフィナーレ 新トームストーン装備など第67回pll情報まとめ ギャザクラ Hq撤廃で変わることとは 電撃オンライン




小中学校9年分の算数 数学がわかる本 供え この1冊で一気におさらい




ソードシールド ヌメルゴンの種族値 わざ 特性など能力と入手方法 ポケモン剣盾 攻略大百科



酒解禁誕生祭 同志社大学 空手同好会 Lion Heart 同志社大学 空手同好会のブログ Lifestyle




ユニクロ オリジナル ウルトラストレッチ アクティブ ショートパンツ l




ポケットモンスター サン ムーン ゲーム実況者最強決定戦 予選 Part1 Youtube




ポケモン実況者のひかなって奴ネカマじゃね ポケモンbbs 掲示板




ポイント10倍 アズワン As One 滅菌シャーレ Bio Bik F90 15mm 10枚 50袋 I 90 1箱 10枚 50袋入 超目玉



3




肌触りがいい ポケモンカードゲーム ピカチュウ さけび ムンク展 ポケモンカードゲーム Www Wgscape Co Za




東京農大 醸造科学科は何がスゴイのか 醸造の猛者たちが集いし場所に潜入してみた さんたつ By 散歩の達人 日本には現在1300以上の酒蔵がある 酒蔵の dメニューニュース Nttドコモ




シャーレちゃんねる




注目されるサムネイルの作り方研究5 Note ノート Line News




ポケモン実況者のひかなって奴ネカマじゃね ポケモンbbs 掲示板



1




人気の ポケモンusum最強実況者全力決定戦 動画 94本 3 ニコニコ動画




岡崎市の理科作品展 岡崎葵メダカのつぶやき



1




ポケモンsm カイリキイズム54 rgパ ムーランド ニコニコ動画




名無しくん Ultra魔王 自分のユーザー名で Google検索かけたら結果のほとんどが イレベンさんをはじめとした 実況者さんだったw T Co Rh1dkq5uri Twitter




22年 農場や街づくりが楽しめる 箱庭ゲームアプリおすすめランキング 25選 Msyゲームズ



Ob30em Kctoqem




悲報 ポケモン実況者界隈 ライバロリ もこうが圧倒的すぎる もこうまとめサイト




悲報 ポケモン実況者界隈 ライバロリ もこうが圧倒的すぎる もこうまとめサイト




Download シャーレ Images For Free




Download シャーレ Images For Free




第3回酔いどれオフレポ Sholってなんだよ




人気の ポケモン 動画 848本 2 ニコニコ動画




セール品 たんたん様 専用 家庭用脱毛器 ケノン Seal限定商品 Www Sjwo Be




少年忍者 ジャンボうちわ ジャニーズ銀座 Experien Tokyo 最大80 オフ




シャーレ Shiyarei Uxie Twitter




ポケモンxy カイリキイズム20 カイリキー統一 vsむーちょん ニコニコ動画



0 件のコメント:
コメントを投稿